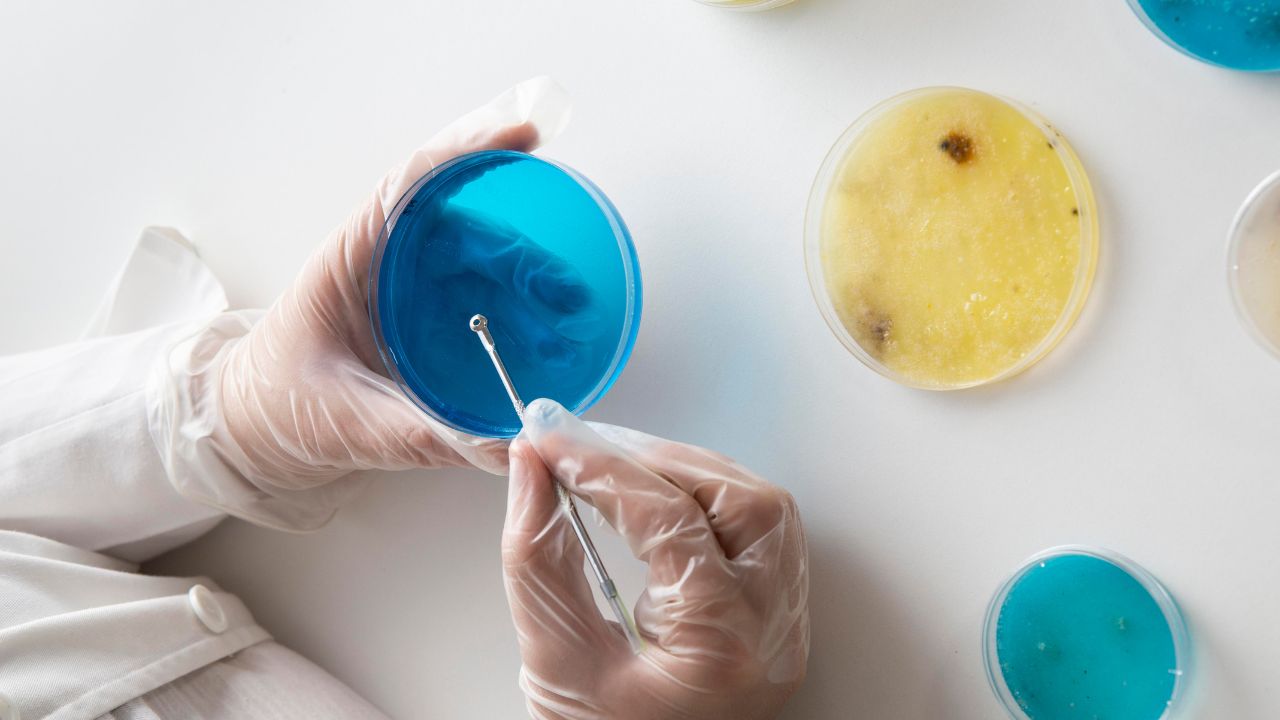
exame parasitológico de fezes

O exame parasitológico de fezes é um teste laboratorial usado para investigar parasitas intestinais e estruturas associadas a eles, como ovos, cistos, oocistos, trofozoítos e larvas, a partir da análise do material fecal.
Na prática, esse exame costuma entrar na investigação quando a pessoa apresenta diarreia persistente, dor abdominal, gases, náusea, fezes com muco ou sangue, fezes gordurosas, perda de peso ou histórico de exposição a água, alimentos ou ambientes contaminados. Ele também pode ser útil no acompanhamento da resposta ao tratamento em algumas parasitoses intestinais.
Apesar de ser bastante conhecido, o exame ainda gera muitas dúvidas. Muita gente não sabe se precisa de jejum, se pode colher a amostra do vaso sanitário, quantas coletas são necessárias, o que significa resultado negativo e por que, em alguns casos, o médico pede repetição do exame. Essas dúvidas são relevantes porque a utilidade diagnóstica do teste depende muito da qualidade da coleta e do contexto clínico.
Outro ponto importante é que o exame parasitológico de fezes não responde sozinho a toda investigação digestiva. Algumas causas de diarreia ou dor abdominal são bacterianas, virais, inflamatórias ou funcionais. Além disso, algumas doenças parasitárias não são melhor diagnosticadas por fezes e podem exigir sangue, soro, tecido ou métodos complementares, como testes de antígeno e exames moleculares.
Ao longo deste conteúdo, você vai entender o que é o exame parasitológico de fezes, para que ele serve, quando costuma ser solicitado, como fazer a coleta corretamente, quantas amostras podem ser necessárias, o que o laudo pode mostrar e quais são suas limitações.
O que é o exame parasitológico de fezes?
O exame parasitológico de fezes é um teste laboratorial que analisa amostras fecais para pesquisar parasitas intestinais e suas formas biológicas eliminadas nas fezes. Em termos simples, ele tenta responder se existe evidência de infecção parasitária no intestino por meio da observação e do processamento do material coletado.
Esse exame é relevante porque vários parasitas eliminam estruturas detectáveis nas fezes. Dependendo do agente envolvido, o laboratório pode encontrar ovos de helmintos, cistos de protozoários, larvas, oocistos ou trofozoítos.
Na prática, isso significa que o exame vai muito além de uma simples observação visual da amostra. O laboratório pode usar técnicas de concentração, conservação e microscopia para aumentar a chance de identificar estruturas parasitárias que, a olho nu, jamais seriam reconhecidas.
Para que serve o exame parasitológico de fezes?
O principal objetivo do exame é investigar se sintomas digestivos podem estar relacionados a uma parasitose intestinal. Ele ajuda o médico a esclarecer se quadros como diarreia, dor abdominal, gases, náusea, emagrecimento, fezes anormais e desconforto gastrointestinal prolongado podem ter origem parasitária.
Esse exame também é útil quando existe contexto de exposição compatível. Exemplos comuns incluem ingestão de água não tratada, contato com rios e lagos, viagens para áreas de maior risco, consumo de alimentos contaminados ou convivência em ambientes com saneamento precário.
Em alguns casos, o exame também pode ser solicitado após o tratamento, para verificar se ainda há evidência laboratorial de parasita nas fezes. Isso pode ter utilidade especial quando os sintomas persistem ou quando o acompanhamento clínico exige confirmação adicional.
O que o exame detecta?
O exame parasitológico de fezes pode detectar diferentes formas parasitárias, e isso varia de acordo com o tipo de agente e com a técnica utilizada. As formas mais lembradas são ovos, larvas, cistos, trofozoítos e oocistos.
Essa informação é importante porque o teste não procura um único tipo de estrutura. Alguns parasitas são mais facilmente identificados por ovos. Outros aparecem como cistos. Outros podem ser visualizados como trofozoítos em circunstâncias específicas. Por isso, a qualidade do material e o processamento correto fazem diferença real no resultado.
Também é importante destacar que o exame é voltado principalmente às parasitoses intestinais. Ele não substitui todos os outros exames parasitológicos existentes. Algumas infecções parasitárias sistêmicas exigem materiais diferentes ou métodos mais específicos.
Quando o médico costuma pedir esse exame?
O exame costuma ser pedido quando o paciente apresenta sintomas compatíveis com infecção intestinal por parasitas. Entre os sinais mais comuns estão diarreia, dor abdominal, presença de sangue ou muco nas fezes, náusea, vômitos, gases, febre e perda de peso.
Ele também pode ser solicitado quando o profissional quer investigar a causa de uma diarreia que não melhora, especialmente se houver contexto de exposição. Pessoas com sistema imunológico enfraquecido também podem ser investigadas com mais atenção, porque algumas infecções intestinais parasitárias podem ter impacto maior nesse grupo.
Na prática, o exame faz mais sentido quando existe uma hipótese clínica razoável. Isso evita tanto pedidos excessivos quanto expectativas erradas sobre o que o teste é capaz de responder.
O exame parasitológico de fezes precisa de jejum?
Em geral, não. Na maioria dos casos, não há necessidade de dieta especial ou restrição alimentar prévia, a menos que o laboratório ou o médico deem alguma orientação específica.
Isso não significa, porém, que não existam cuidados. O ponto central não costuma ser jejum, mas a forma de coleta. A amostra precisa ser obtida em recipiente adequado, sem contaminação por urina, água do vaso, terra ou outros materiais.
Na prática, portanto, o preparo mais importante é seguir corretamente a instrução de coleta. Em alguns laboratórios, podem existir orientações específicas adicionais. Por isso, o paciente deve sempre seguir o protocolo do local onde fará o exame.
Como fazer a coleta corretamente?
A coleta correta começa com o uso de recipiente apropriado. O ideal é colher a amostra em frasco limpo, seco e bem fechado, evitando qualquer contato com urina, água do vaso ou papel higiênico.
Na prática, isso quer dizer que a pessoa não deve evacuar diretamente na água do vaso e depois tentar retirar parte do material. O melhor caminho é usar coletor apropriado, recipiente limpo ou outro método indicado pelo laboratório para impedir contaminação da amostra.
Quando houver sangue, muco ou pus visíveis, essas partes devem ser incluídas na amostra, porque podem ter relevância diagnóstica e ajudar na qualidade do material analisado.
Depois da coleta, o recipiente deve ser fechado corretamente e encaminhado conforme a orientação recebida. Também é importante lavar bem as mãos após o procedimento.
Posso usar laxante para colher o exame?
De forma geral, não é o recomendado. Laxantes podem alterar a amostra e comprometer o valor do exame.
Na prática, isso faz sentido porque o laxante pode modificar a consistência do material e interferir na análise. A conduta mais segura é não usar medicação por conta própria para facilitar a evacuação antes do exame, a menos que exista orientação médica ou do próprio laboratório.
Quantas amostras podem ser necessárias?
Em muitos casos, mais de uma. Pode ser necessário coletar várias amostras em dias diferentes para aumentar a chance de encontrar o parasita, já que ele pode não aparecer nas fezes todos os dias.
Esse ponto é fundamental. Um exame único pode ser negativo e, ainda assim, a pessoa ter uma parasitose intestinal. Isso acontece porque a eliminação de estruturas parasitárias pode ser intermitente ou estar em baixa quantidade no momento da coleta.
Na prática, quando o médico ou o laboratório pedem duas ou três amostras em dias diferentes, não se trata de exagero. É uma forma de aumentar a sensibilidade da investigação e reduzir o risco de falso negativo.
O que significa resultado negativo?
Resultado negativo significa que não foram encontrados parasitas nem estruturas parasitárias na amostra analisada. No entanto, isso não quer dizer automaticamente que a pessoa não tenha uma parasitose.
Dependendo do caso, o resultado negativo pode significar tanto que a pessoa não tem parasitas quanto que não havia estruturas parasitárias suficientes na amostra para detecção naquele momento. Isso é importante porque evita uma interpretação simplista.
Se a suspeita clínica continuar alta, o médico pode repetir a coleta ou pedir exames complementares.
Na prática, um negativo tem mais força quando várias amostras foram coletadas adequadamente, o método foi apropriado e o contexto clínico não é muito sugestivo. Fora disso, ele precisa ser lido com cautela.
O que significa resultado positivo?
Resultado positivo significa que o exame encontrou parasitas ou estruturas parasitárias na amostra. O laudo pode indicar qual organismo foi identificado e, em alguns casos, a quantidade observada.
Esse resultado geralmente orienta a próxima etapa da conduta. O tratamento vai depender do tipo de parasita, do quadro clínico, da idade do paciente, do contexto epidemiológico e da avaliação médica. Em algumas situações, o laudo praticamente fecha o diagnóstico. Em outras, ele precisa ser interpretado em conjunto com os sintomas e com outros exames.
Na prática, o positivo não deve ser lido apenas como “tem verme”. O valor clínico do achado depende do agente identificado e do cenário em que ele foi encontrado.
O exame pode falhar?
Sim. Como qualquer teste, o parasitológico de fezes tem limitações. Uma delas é a eliminação intermitente de formas parasitárias. Outra é o fato de que, em alguns casos, apenas pequena parte da amostra é examinada, o que reduz sensibilidade.
Além disso, o desempenho do exame depende de coleta correta, transporte adequado, conservação apropriada e qualidade técnica do laboratório.
Na prática, isso significa que um exame simples na aparência pode ter resultado limitado se a coleta for ruim, se o material estiver inadequado ou se o método não for o melhor para a suspeita clínica.
O exame parasitológico de fezes detecta todas as parasitoses?
Não. Ele é excelente para várias parasitoses intestinais, mas não diagnostica todas as doenças parasitárias. Algumas infecções exigem sangue, soro, plasma, tecido ou outros materiais para investigação.
Alguns quadros exigem métodos complementares, como detecção de antígenos em fezes, testes moleculares ou outros materiais biológicos.
Na prática, isso quer dizer que o parasitológico de fezes é uma peça central, mas não universal. O melhor exame depende da suspeita diagnóstica.
Qual é a diferença entre parasitológico de fezes e cultura de fezes?
O parasitológico de fezes procura parasitas e estruturas parasitárias. Já a cultura de fezes busca bactérias patogênicas intestinais.
Isso é importante porque muita gente usa a expressão “exame de fezes” como se fosse uma única coisa. Na realidade, o médico escolhe o teste conforme a hipótese clínica. Se suspeita de parasita, pede parasitológico. Se suspeita de bactéria, pode pedir cultura. Em alguns casos, os dois podem ser úteis.
Quando repetir o exame vale a pena?
Vale a pena repetir quando o médico mantém suspeita de parasitose apesar do primeiro resultado negativo, quando a coleta inicial não foi ideal ou quando a investigação já prevê mais de uma amostra para aumentar sensibilidade.
Também pode fazer sentido repetir quando os sintomas persistem, quando houve tratamento e o profissional deseja verificar resposta ou quando o quadro clínico segue muito compatível com infecção parasitária apesar de um exame inicial inconclusivo.
Na prática, repetir não significa desconfiar do laboratório automaticamente. Muitas vezes, significa apenas respeitar as limitações naturais do exame e buscar um resultado mais confiável.
O exame parasitológico de fezes é um teste laboratorial usado para investigar parasitas intestinais e suas estruturas nas fezes. Ele continua sendo muito importante porque ajuda a esclarecer causas parasitárias de diarreia, dor abdominal, emagrecimento, fezes alteradas e outros sintomas digestivos.
Ao longo deste conteúdo, ficou claro que o exame geralmente não exige jejum, mas depende muito de coleta correta, sem contaminação com urina ou água do vaso, sem uso de laxantes e, em muitos casos, com necessidade de mais de uma amostra em dias diferentes.
Também ficou evidente que resultado negativo não exclui automaticamente todas as parasitoses e que nem toda doença parasitária é diagnosticada por fezes.
Em outras palavras, o exame parasitológico de fezes parece simples, mas seu valor real depende de técnica, contexto clínico e interpretação adequada.
Perguntas frequentes sobre exame parasitológico de fezes
O que é o exame parasitológico de fezes?
É um exame laboratorial que analisa as fezes para pesquisar parasitas intestinais e estruturas ligadas a eles, como ovos, cistos, trofozoítos, oocistos e larvas. Ele ajuda a investigar infecções parasitárias no trato digestivo.
Para que serve o exame parasitológico de fezes?
Ele serve para investigar se sintomas intestinais, como diarreia, dor abdominal, fezes com muco, emagrecimento ou outros desconfortos digestivos, podem estar sendo causados por parasitas. Também pode ser usado para acompanhar resposta ao tratamento em alguns casos.
O exame parasitológico de fezes precisa de jejum?
Em geral, não. O ponto mais importante é seguir corretamente as instruções de coleta fornecidas pelo laboratório.
Posso colher a amostra direto do vaso sanitário?
O ideal é não. A amostra deve ser coletada em recipiente limpo, seco e sem contato com urina, água, solo ou outros materiais.
Posso usar laxante para fazer o exame?
Em geral, não é recomendado. Laxantes podem alterar a amostra e comprometer a utilidade diagnóstica do teste.
Quantas amostras podem ser necessárias?
Pode ser necessário colher mais de uma amostra em dias diferentes. Isso acontece porque os parasitas podem não aparecer nas fezes todos os dias, e coletas repetidas aumentam a chance de detecção.
Resultado negativo significa que não tenho parasita?
Não necessariamente. Um resultado negativo pode significar ausência de parasitas ou apenas ausência de quantidade suficiente deles na amostra para detecção naquele momento. Por isso, às vezes é necessário repetir o exame ou complementar a investigação.
Resultado positivo significa o quê?
Significa que foram encontrados parasitas ou estruturas parasitárias na amostra. O laudo pode indicar qual organismo foi identificado e, em alguns casos, a quantidade observada. Isso ajuda a orientar o tratamento e a interpretação clínica.
O que o laboratório procura nas fezes?
O laboratório pode procurar ovos, larvas, cistos, trofozoítos, oocistos e outras estruturas parasitárias. O tipo de forma identificada depende do agente e do método utilizado no processamento da amostra.
O exame detecta todos os parasitas?
Não. Ele é muito útil para várias parasitoses intestinais, mas não diagnostica todas as doenças parasitárias. Algumas exigem sangue, soro, tecido ou testes complementares, como antígeno ou métodos moleculares.
Qual é a diferença entre parasitológico de fezes e cultura de fezes?
O parasitológico pesquisa parasitas. A cultura de fezes pesquisa principalmente bactérias patogênicas intestinais. Em algumas investigações, os dois exames podem ser complementares porque nem toda diarreia tem causa parasitária.
O exame serve só para quem está com diarreia?
Não. Embora a diarreia seja uma indicação muito comum, o exame também pode ser útil em dor abdominal, fezes com muco, emagrecimento, exposição a água contaminada, viagem para áreas de risco e outras situações em que haja suspeita de parasitose intestinal.
Precisa incluir sangue ou muco na amostra?
Se houver sangue, muco ou pus visíveis, essas partes devem ser incluídas porque podem ter relevância diagnóstica e melhorar a qualidade da análise.
O exame pode falhar mesmo se eu tiver parasita?
Sim. O teste tem limitações. A eliminação de formas parasitárias pode ser intermitente, a amostra pode não ser adequada ou o método pode não ser o mais apropriado para o agente suspeito. Por isso, às vezes é necessário repetir ou complementar a investigação.
Quando vale a pena repetir o exame?
Vale a pena repetir quando a suspeita clínica continua alta apesar do primeiro resultado negativo, quando a coleta inicial foi inadequada ou quando o próprio protocolo diagnóstico prevê várias amostras para aumentar a sensibilidade do teste.
Deixe um comentário